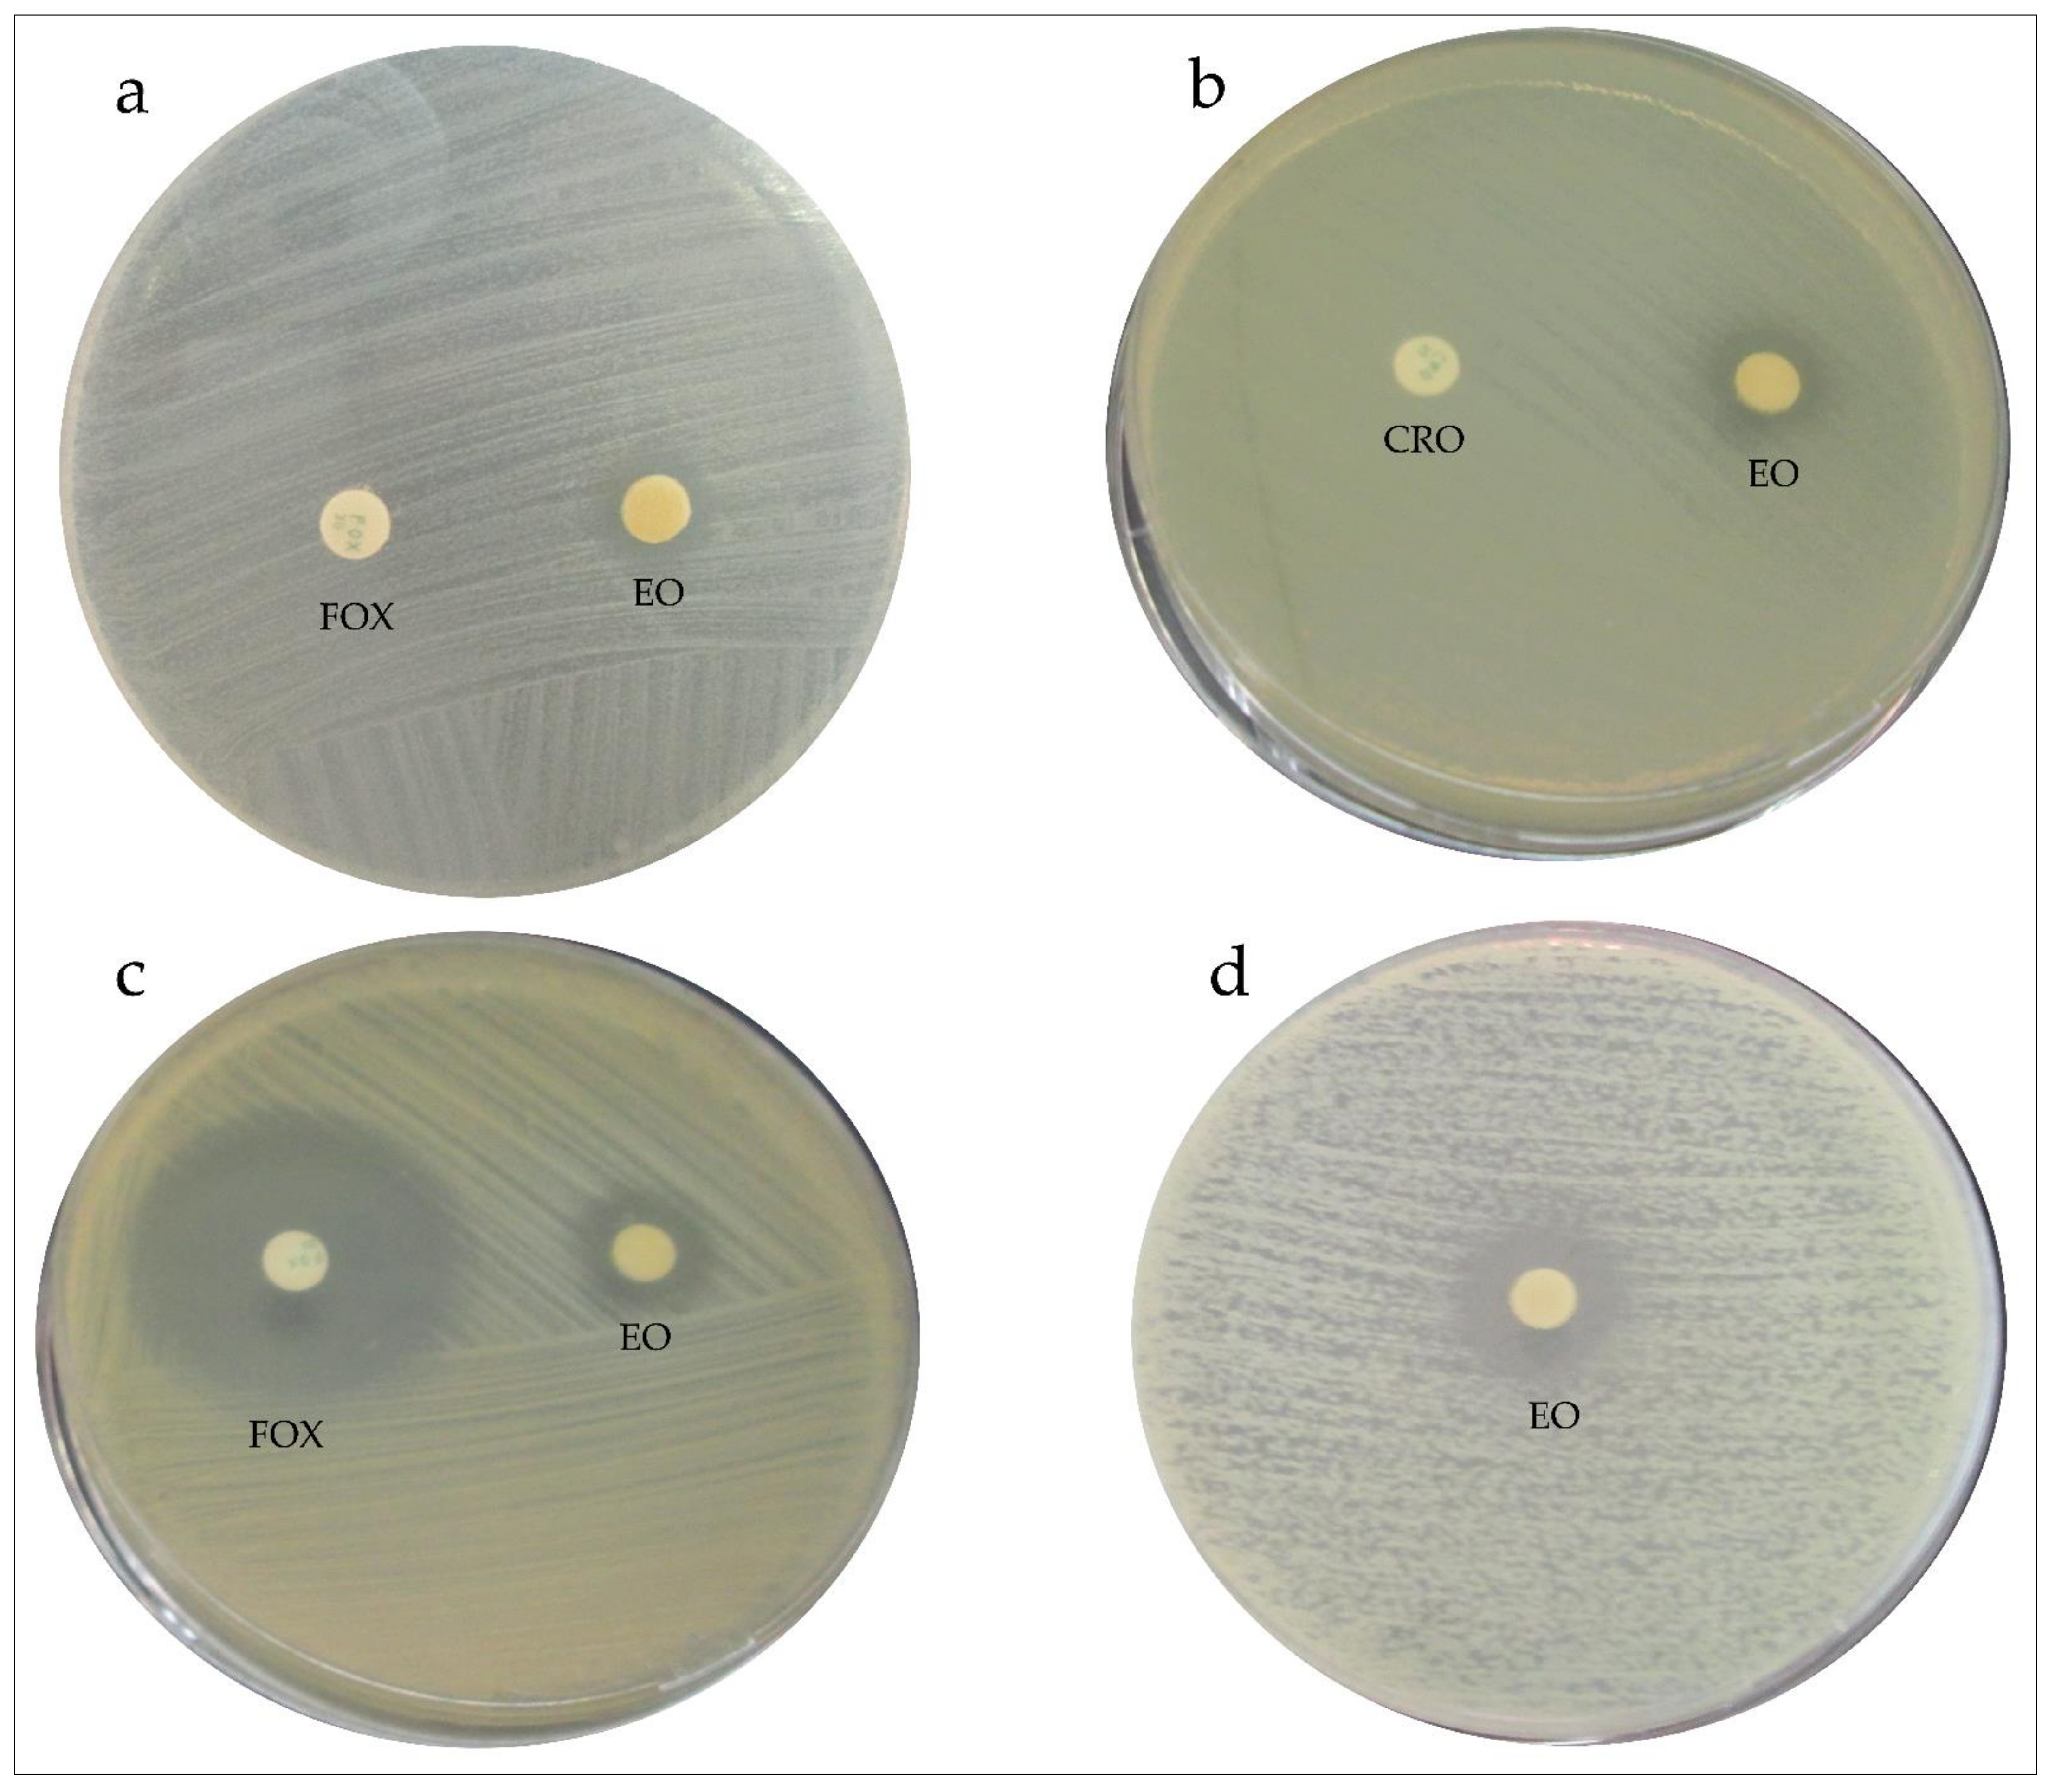

Chemical Composition, Antioxidant, and Antibacterial Activities of Essential Oil of Atriplex semibaccata R.Br. Aerial Parts: First Assessment against Multidrug-Resistant Bacteria
Abstract
1. Introduction
2. Materials and Methods
2.1. Plant Material and Essential Oil (EO) Extraction
2.2. Gas Chromatography–Mass Spectrometric (GC–MS) Analysis
2.3. Antioxidant Activity
2.3.1. Free Radical-Scavenging Activity Using 2,2-Diphenyl-1-Picrylhydrazyl (DPPH)
2.3.2. Reducing-Power Assay
2.4. Antibacterial Activity
2.4.1. Microorganism Strains
2.4.2. Antibacterial Screening
2.4.3. Determination of the Minimal Inhibitory Concentration (MIC)
2.4.4. Determination of Minimal Bactericidal Concentration (MBC)
2.4.5. Synergistic Interaction between EO from A. Semibaccata and Conventional Antibacterials
3. Results and Discussion
3.1. EO Composition
3.2. Antioxidant Activity
3.3. Antibacterial Activity
3.4. Synergistic Interactions between A. semibaccata EO and Conventional Antibiotics
4. Conclusions
Author Contributions
Funding
Institutional Review Board Statement
Informed Consent Statement
Data Availability Statement
Acknowledgments
Conflicts of Interest
References
- Lewis, S.M.; Kelly, M. Mapping the potential for biofuel production on marginal lands: Differences in definitions, data and models across scales. ISPRS Int. J. Geoinf. 2014, 3, 430–459. [Google Scholar] [CrossRef]
- Mirck, J.; Zalesny, R.S. Mini-review of knowledge gaps in salt tolerance of plants applied to willows and poplars. Int. J. Phytoremediation 2015, 17, 640–650. [Google Scholar] [CrossRef]
- Major, J.E.; Mosseler, A.; Malcolm, J.W.; Heartz, S. Salinity tolerance of three Salix species: Survival, biomass yield and allocation, and biochemical efficiencies. Biomass Bioenergy 2017, 105, 10–22. [Google Scholar] [CrossRef]
- Ramakrishna, W.; Rathore, P.; Kumari, R.; Yadav, R. Brown gold of marginal soil: Plant growth promoting bacteria to overcome plant abiotic stress for agriculture, biofuels and carbon sequestration. Sci. Total Environ. 2020, 711, 135062. [Google Scholar] [CrossRef]
- Angelova, V.R.; Grekov, D.F.; Kisyov, V.K.; Ivanov, K.I. Potential of lavender (Lavandula vera L.) for phytoremediation of soils contaminated with heavy metals. Int. J. Agric. Biosyst. Eng. 2015, 9, 133–155. [Google Scholar] [CrossRef]
- Von Cossel, M.; Lewandowski, I.; Elbersen, B.; Staritsky, I.; Van Eupen, M.; Iqbal, Y.; Mantel, S.; Scordia, D.; Testa, G.; Cosentino, S.L.; et al. Marginal agricultural land low-input systems for biomass production. Energies 2019, 12, 3123. [Google Scholar] [CrossRef]
- Von Cossel, M.; Wagner, M.; Lask, J.; Magenau, E.; Bauerle, A.; Von Cossel, V.; Warrach-Sagi, K.; Elbersen, B.; Staritsky, I.; van Eupen, M.; et al. Prospects of bioenergy cropping systems for a more social-ecologically sound bioeconomy. Agronomy 2019, 9, 605. [Google Scholar] [CrossRef]
- Fitzsimmons, K.; Lovely, C.; Glenn, E. Growth differences among widely separated geographic accessions of fourwing saltbush (Atriplex canescens) in the Great Basin Desert, New Mexico, USA. Arid Soil Res. Rehabil. 1998, 12, 87–94. [Google Scholar] [CrossRef]
- Chao, J.; Dai, Y.; Verpoorte, R.; Lam, W.; Cheng, Y.C.; Pao, L.H.; Zhang, W.; Chen, S. Major achievements of evidence-based traditional Chinese medicine in treating major diseases. Biochem. Pharmacol. 2017, 139, 94–104. [Google Scholar] [CrossRef]
- Kang, Y.M.; Komakech, R.; Karigar, C.S.; Saqib, A. Traditional Indian medicine (TIM) and traditional Korean medicine (TKM): Aconstitutional-based concept and comparison. Integr. Med. Res. 2017, 6, 105–113. [Google Scholar] [CrossRef] [PubMed]
- Nimrouzi, M.; Jaladat, A.M.; Zarshenas, M.M. A panoramic view of medicinal plants traditionally applied for impotence and erectile dysfunction in Persian medicine. J. Tradit. Complement. Med. 2020, 10, 7–12. [Google Scholar] [CrossRef]
- Liao, X.; Bu, Y.; Jia, Q. Traditional Chinese medicine as supportive care for the management of liver cancer: Past, present, and future. Genes Dis. 2020, 7, 370–379. [Google Scholar] [CrossRef]
- Siddiqui, B.S.; Ahmed, S.; Ghiasuddin, M.; Khan, A.U. Triterpenoids of Atriplex stocksii. Phytochemistry 1994, 37, 1123–1125. [Google Scholar] [CrossRef]
- Ksouri, R.; Ksouri, W.M.; Jallali, I.; Debez, A.; Magné, C.; Hiroko, I.; Abdelly, C. Medicinal halophytes: Potent source of health promoting biomolecules with medical, nutraceutical and food applications. Crit. Rev. Biotechnol. 2012, 32, 289–326. [Google Scholar] [CrossRef]
- Coates, A.; Hu, Y.; Bax, R.; Page, C. The future challenges facing the development of new antimicrobial drugs. Nat. Rev. Drug Discov. 2002, 1, 895–910. [Google Scholar] [CrossRef] [PubMed]
- Wikaningtyas, P.; Sukandar, E.Y. The antibacterial activity of selected plants towards resistant bacteria isolated from clinical specimens. Asian Pac. J. Trop. Biomed. 2016, 6, 16–19. [Google Scholar] [CrossRef]
- Mulyaningsih, S.; Sporer, F.; Reichling, J.; Wink, M. Antibacterial activity of essential oils from Eucalyptus and of selected components against multidrug-resistant bacterial pathogens. Pharm. Biol. 2011, 49, 893–899. [Google Scholar] [CrossRef] [PubMed]
- Ibrahimi, M.; Korichi, W.; Hafidi, M.; Lemee, L.; Ouhdouch, Y.; Loqman, S. Marine actinobacteria: Screening for predation leads to the discovery of potential new drugs against multidrug-resistant bacteria. Antibiotics 2020, 9, 91. [Google Scholar] [CrossRef]
- Ibrahimi, M.; Korichi, W.; Loqman, S.; Hafidi, M.; Ouhdouch, Y.; Lemee, L. Thermochemolysis—GC-MS as a tool for chemotaxonomy and predation monitoring of a predatory actinobacteria against a multidrug resistant bacteria. J. Anal. Appl. Pyrolysis 2020, 145, 104740. [Google Scholar] [CrossRef]
- Hemaiswarya, S.; Kruthiventi, A.K.; Doble, M. Synergism between natural products and antibiotics against infectious diseases. Phytomedicine 2008, 15, 639–652. [Google Scholar] [CrossRef]
- Ait Dra, L.; Ait Sidi Brahim, M.; Boualy, B.; Aghraz, A.; Barakate, M.; Oubaassine, S.; Markouk, M.; Larhsini, M. Chemical composition, antioxidant and evidence antimicrobial synergistic effects of Periploca laevigata essential oil with conventional antibiotics. Ind. Crops Prod. 2017, 109, 746–752. [Google Scholar] [CrossRef]
- Lal, K.; Yadav, R.K.; Kaur, R.; Bundela, D.S.; Khan, M.I.; Chaudhary, M.; Meena, R.L.; Dar, S.R.; Singh, G. Productivity, essential oil yield, and heavy metal accumulation in lemon grass (Cymbopogon flexuosus) under varied wastewater-groundwater irrigation regimes. Ind. Crops Prod. 2013, 45, 270–278. [Google Scholar] [CrossRef]
- Zheljazkov, V.D.; Craker, L.E.; Xing, B. Effects of Cd, Pb, and Cu on growth and essential oil contents in dill, peppermint, and basil. 2006; 58, 9–16. [Google Scholar] [CrossRef]
- The Angiosperm Phylogeny Group. An update of the Angiosperm Phylogeny Group classification for the orders and families of flowering plants: APG IV. Bot. J. Linn. Soc. 2016, 181, 1–20. [Google Scholar] [CrossRef]
- Heuzé, V.; Thiollet, H.; Tran, G. Creeping Saltbush (Atriplex semibaccata). Feedipedia, a Programme by INRAE, CIRAD, AFZ and FAO. 2016. Available online: https://www.feedipedia.org/node/183 (accessed on 2 November 2016).
- Le Houérou, H.N. Le rôle d’ Atriplex spp. dans la réhabilitation des terres arides dans le bassin méditerranéen: Revue. Systèmes agroforestiers 1992, 18, 107–148. [Google Scholar] [CrossRef]
- Sahin, F.; Güllüce, M.; Daferera, D.; Sökmen, A.; Sökmen, M.; Polissiou, M.; Agar, G.; Özer, H. Biological activities of the essential oils and methanol extract of Origanum vulgare ssp. vulgare in the Eastern Anatolia region of Turkey. Food Control 2004, 15, 549–557. [Google Scholar] [CrossRef]
- Oyaizu, M. Studies on products of browning reactions: Antioxidative activities of product of browning reaction prepared from glucosamine. Jpn. J. Nutr. Diet. 1986, 44, 307–315. [Google Scholar] [CrossRef]
- Clinical and Laboratory Standards Institute (CLSI. Methods for Dilution Antimicrobial Susceptibility Tests for Bacteria That Grow Aerobically: Approved Standard; CLSI: Wayne, PA, USA, 2015. [Google Scholar]
- Clinical and Laboratory Standards Institute (CLSI). Performance Standards for Antimicrobial Disk Susceptibility Tests: Approved Standard, 12th ed.; CLSI: Wayne, PA, USA, 2011. [Google Scholar]
- Clinical and Laboratory Standards Institute (CLSI). Performances for Antimicrobial Susceptibility Testing: Twenty-First Informational Supplement-M 100-S21; CLSI: Wayne, PA, USA, 2015. [Google Scholar]
- Didry, N.; Dubreuil, L.; Pinkas, M. Microbiological properties of protoanemonin isolated from Ranunculus bulbosus. Phyther. Res. 1993, 7, 21–24. [Google Scholar] [CrossRef]
- Jeong, J.B.; Jeong, H.J. 2-Methoxy-4-vinylphenol can induce cell cycle arrest by blocking the hyper-phosphorylation of retinoblastoma protein in benzo[a]pyrene-treated NIH3T3 cells. Biochem. Biophys. Res. Commun. 2010, 400, 752–757. [Google Scholar] [CrossRef]
- Jeong, J.B.; Hong, S.C.; Jeong, H.J.; Koo, J.S. Anti-inflammatory effect of 2-methoxy-4-vinylphenol via the suppression of NF-κB and MAPK activation, and acetylation of histone H3. Arch. Pharm. Res. 2011, 34, 2109–2116. [Google Scholar] [CrossRef]
- Rodriguez, S.A.; Murray, A.P. Antioxidant activity and chemical composition of essential oil from Atriplex undulata. Nat. Prod. Commun. 2010, 5, 1841–1844. [Google Scholar] [CrossRef]
- Bylka, W.; Stobiecki, M.; Frański, R. Sulphated flavonoid glycosides from leaves of Atriplex hortensis. Acta Physiologiae Plantarum 2001, 23, 285–290. [Google Scholar] [CrossRef]
- Bylka, W. A new acylated flavonol diglycoside from Atriplex littoralis. Acta Physiologiae Plantarum 2004, 26, 393–398. [Google Scholar] [CrossRef]
- Al-Jaber, N.A.A.; Mujahid, T.G.; Al-Hazmi, H.M.G. Secondary metabolites of chenopodiaceae species. J. Chem. Soc. Pak. 1992, 14, 76–83. [Google Scholar]
- Awaad, A.S.; Maitland, D.J.; Donia, A.E.R.M.; Alqasoumi, S.I.; Soliman, G.A. Novel flavonoids with antioxidant activity from a Chenopodiaceous plant. Pharm. Biol. 2012, 50, 99–104. [Google Scholar] [CrossRef]
- El Souda, S.S.E.D.; Matloub, A.A.; Nepveu, F.; Valentin, A.; Roques, C. Phenolic composition and prospective anti-infectious properties of Atriplex lindleyi. Asian Pac. J. Trop. Dis. 2015, 5, 786–791. [Google Scholar] [CrossRef]
- Kamal, Z.; Ullah, F.; Ayaz, M.; Sadiq, A.; Ahmad, S.; Zeb, A.; Hussain, A.; Imran, M. Anticholinesterse and antioxidant investigations of crude extracts, subsequent fractions, saponins and flavonoids of Atriplex laciniata L.: Potential effectiveness in Alzheimer’s and other neurological disorders. Biol. Res. 2015, 48, 1–11. [Google Scholar] [CrossRef]
- Aissi, O.; Boussaid, M.; Messaoud, C. Essential oil composition in natural populations of Pistacia lentiscus L. from Tunisia: Effect of ecological factors and incidence on antioxidant and antiacetylcholinesterase activities. Ind. Crops Prod. 2016, 91, 56–65. [Google Scholar] [CrossRef]
- Benhammou, N.; Bekkara, F.A.; Kadifkova Panovska, T. Antioxidant activity of methanolic extracts and some bioactive compounds of Atriplex halimus. Comptes Rendus Chim. 2009, 12, 1259–1266. [Google Scholar] [CrossRef]
- Gamal, A.S.; Donia, A.M. Antihyperglycemic, antihyperlipidemic and antioxidant effect of Atriplex farinosa and Atriplex nummularia in streptozotocin induced diabetes in rats. Bull. Environ. Pharmacol. Life Sci. 2015, 4, 10–18. [Google Scholar]
- Porthouse, A.; Smith, R.G.; Rogers, T. Gentamicin resistance in Staphylococcus aureus. Lancet 1976, 20–21. [Google Scholar] [CrossRef]
- Rastogi, V.; Nirwan, P.S.; Jain, S.; Kapil, A. Nosocomial outbreak of septicaemia in neonatal intensive care unit due to extended spectrum β-lactamase producing Klebsiella pneumoniae showing multiple mechanisms of drug resistance. Indian J. Med. Microbiol. 2010, 28, 380–384. [Google Scholar] [CrossRef]
- Ibrahim, D.R.; Dodd, C.E.R.; Stekel, D.J.; Ramsden, S.J.; Hobman, J.L. Multidrug resistant, extended spectrum β-lactamase (ESBL)-producing Escherichia coli isolated from a dairy farm. FEMS Microbiol. Ecol. 2016, 92, 1–13. [Google Scholar] [CrossRef]
- Sanchez, G.V.; Master, R.N.; Clark, R.B.; Fyyaz, M.; Duvvuri, P.; Ekta, G.; Bordon, J. Klebsiella pneumoniae antimicrobial drug resistance. Emerg. Infect. Dis. 2013, 19, 133–136. [Google Scholar] [CrossRef] [PubMed]
- Wei, J.; Wenjie, Y.; Ping, L.; Na, W.; Haixia, R.; Xuequn, Z. Antibiotic resistance of Klebsiella pneumoniae through β-arrestin recruitment-induced β-lactamase signaling pathway. Exp. Ther. Med. 2018, 15, 2247–2254. [Google Scholar] [CrossRef] [PubMed]
- Benzarti, M.; Rejeb, K.B.; Debez, A.; Abdelly, C. Environmental and Economical Opportunities for the Valorisation of the Genus Atriplex: New Insights; Hakeem, K.R., Ahmad, P., Ozturk, M., Eds.; Springer US: Boston, MA, USA, 2013; ISBN 978-1-4614-7027-4. [Google Scholar]
- Anyasor, G.; Onajobi, F.; Osilesi, O.; Adebawo, O.; Oboutor, E. Chemical constituents in n-butanol fractions of Castus afer ker Gawl leaf and stem. J. Intercult. Ethnopharmacol. 2014, 3, 78. [Google Scholar] [CrossRef] [PubMed]
- Duke, J.A. Handbook of Phytochemical Constituents of GRAS Herbs and Other Economic Plants, 2nd ed.; CRC Press: Boca Raton, FL, USA, 1992; p. 335. [Google Scholar]
- Alamri, A.; El-Newehy, M.H.; Al-Deyab, S.S. Biocidal polymers: Synthesis and antimicrobial properties of benzaldehyde derivatives immobilized onto amine-terminated polyacrylonitrile. Chem. Cent. J. 2012, 6, 1–13. [Google Scholar] [CrossRef] [PubMed]
- Cole, L.K.; Luu, D.H.; Rajala-Schultz, P.J.; Meadows, C.; Torres, A.H. In vitro activity of an ear rinse containing tromethamine, EDTA, and benzyl alcohol on bacterial pathogens from dogs with otitis. Am. J. Vet. Res. 2006, 67, 1040–1044. [Google Scholar] [CrossRef]
- Meyer, B.K.; Ni, A.; Hu, B.; Shi, L. Antimicrobial preservative use in parenteral products: Past and present. J. Pharm. Sci. 2007, 96, 3155–3167. [Google Scholar] [CrossRef] [PubMed]
- Friedman, M.; Henika, P.R.; Mandrell, R.E. Antibacterial activities of phenolic benzaldehydes and benzoic acids against Campylobacter jejuni, Escherichia coli, Listeria monocytogenes, and Salmonella enterica. J. Food Prot. 2003, 66, 1811–1821. [Google Scholar] [CrossRef] [PubMed]
- Ullah, I.; Khan, A.L.; Ali, L.; Khan, A.R.; Waqas, M.; Hussain, J.; Lee, I.J.; Shin, J.H. Benzaldehyde as an insecticidal, antimicrobial, and antioxidant compound produced by Photorhabdus temperata M1021. J. Microbiol. 2015, 53, 127–133. [Google Scholar] [CrossRef]
- O’Neil, M.J.; Smith, A.; Heckelman, P.E.; Budavari, S. The Merck Index—An Encyclopedia of Chemicals, Drugs, and Biologicals; Merck and Co: Whitehouse Station, NJ, USA, 2001; Volume 767, p. 4342. [Google Scholar]
- Lang, G.; Buchbauer, G. A review on recent research results (2008–2010) on essential oils as antimicrobials and antifungals. A review. Flavour Fragr. J. 2012, 27, 13–39. [Google Scholar] [CrossRef]
- Gadisa, E. Combined antibacterial effect of essential oils from three most commonly used Ethiopian traditional medicinal plants on selected multidrug resistant bacteria. BMC Complement. Altern. Med. 2015, 4, 1–9. [Google Scholar]
- Yap, P.S.X.; Yiap, B.C.; Ping, H.C.; Lim, S.H.E. Essential oils, a new horizon in combating bacterial antibiotic resistance. Open Microbiol. J. 2014, 8, 6–14. [Google Scholar] [CrossRef] [PubMed]
- Sienkiewicz, M.; Łysakowska, M.; Kowalczyk, E.; Szymańska, G.; Kochan, E.; Krukowska, J.; Olszewski, J.; Zielińska-Bliźniewska, H. The ability of selected plant essential oils to enhance the action of recommended antibiotics against pathogenic wound bacteria. Burns 2017, 43, 310–317. [Google Scholar] [CrossRef]
- Adwan, G.M.; Abu-Shanab, B.A.; Adwan, K.M. In vitro activity of certain drugs in combination with plant extracts against Staphylococcus aureus infections. Afr. J. Biotechnol. 2009, 8, 4239–4241. [Google Scholar] [CrossRef]
- De Oliveira, S.M.S.; Falcão-Silva, V.S.; Siqueira-Junior, J.P.; de Carvalho Costa, M.J.; de Melo Diniz, M.d.F.F. Modulation of drug resistance in Staphylococcus aureus by extract of mango (Mangifera indica) peel. Braz. J. Pharmacogn. 2011, 21, 190–193. [Google Scholar] [CrossRef]
- Toroglu, S. In-vitro antimicrobial activity and synergistic/antagonistic effect of interactions between antibiotics and some spice essential oils. J. Environ. Biol. 2011, 32, 23–29. [Google Scholar] [PubMed]
- Aleksic, V.; Mimica-Dukic, N.; Simin, N.; Nedeljkovic, N.S.; Knezevic, P. Synergistic effect of Myrtus communis L. essential oils and conventional antibiotics against multi-drug resistant Acinetobacter baumannii wound isolates. Phytomedicine 2014, 21, 1666–1674. [Google Scholar] [CrossRef]

| No. | Compound | Content % | RT | RI Exp. | RI Lit. |
|---|---|---|---|---|---|
| 1 | Benzyl alcohol | 6.3 | 8.3 | 1040 | 1037 |
| 2 | Cyclohexanone | 0.4 | 12.3 | 945 | 891 |
| 3 | 3,10-Dioxatricyclo [4.3.1.0(2,4)]dec-7-ene | 0.6 | 7.4 | 964 | 964 |
| 4 | 1-Methylcycloheptanol | 1.5 | 10.9 | 1010 | 1009 |
| 5 | Cycloocta-2.5-dien-1-ol | 0.2 | 4.0 | 1103 | 1112 |
| 6 | 3,4-Dimethylcyclohexanol | 0.7 | 10.7 | 1126 | 1126 |
| 7 | (2-Bromoethyl)cyclohexane | 0.2 | 27.5 | 1176 | 1176 |
| 8 | Cyclohexanone, 2-(2-butynyl)- | 0.1 | 20.8 | 1264 | 1267 |
| 9 | 1-Cyclohexene-1-carboxaldehyde, 5,5-dimethyl-3-oxo | 0.1 | 12.2 | 1285 | 1285 |
| 10 | Bicyclo[3.1.0]hexane-6-methanol,2-hydroxy-1,4,4-trimethyl- | 0.2 | 14.2 | 1322 | 1330 |
| 11 | 2-Butanone, 4-(2,6,6-trimethyl-1,3-cyclohexadien-1-yl)- | 0.5 | 23.4 | 1424 | 1425 |
| 12 | 1,3-Heptadiene, 2,3-dimethyl | 0.4 | 10.2 | 868 | 866 |
| 13 | 2,4-Heptadienal, (E,E)- | 0.4 | 7.6 | 1005 | 1012 |
| 14 | Damascenone | 0.5 | 22.1 | 1338 | 1820 |
| 15 | Linalool oxide | 1.2 | 9.6 | 1067 | 1061 |
| 16 | Linalool | 0.2 | 10.6 | 1098 | 1099 |
| 17 | Endo-borneol | 0.1 | 13.1 | 1165 | 1162.6 |
| 18 | m-Cymen-8-ol | 0.6 | 13.9 | 1176 | 1182 |
| 19 | Safranal | 0.4 | 14.5 | 1212 | 1207 |
| 20 | Ascaridole epoxide | 0.2 | 18.7 | 1220 | 1234 |
| 21 | Cis-p-mentha-1(7),8-dien-2-ol | 0.1 | 4.8 | 1227 | 1185 |
| 22 | Cis-p-Mentha-1(7),8-dien-2-ol | 0.2 | 13.3 | 1231 | 1175 |
| 23 | p-Cymen-7-ol | 0.3 | 20.0 | 1289 | 1287 |
| 24 | Trans-α-ionone | 0.8 | 26.2 | 1422 | 1430 |
| 25 | Geranyl acetone | 0.2 | 24.9 | 1453 | 1455 |
| 26 | Ionone | 0.3 | 17.7 | 1493 | 1425.6 |
| 27 | Linalool oxide | 0.2 | 9.7 | 1513 | 1446 |
| 28 | 3-Hydroxy-β-damascone | 0.2 | 31.2 | 1618 | 1640 |
| 29 | L-Menthone | 0.2 | 12.7 | 1148 | 1136 |
| 30 | Isospathulenol | 1.1 | 22.2 | 1624 | 1625.6 |
| 31 | Hexahydrofarnesyl acetone | 0.4 | 39.9 | 1697 | 1833 |
| 32 | p-Xylene | 0.5 | 4.4 | 865 | 863.5 |
| 33 | o-Xylene | 2.1 | 4.2 | 890 | 882.4 |
| 34 | Benzaldehyde | 6.8 | 6.1 | 977 | 976 |
| 35 | 2-Nitroheptenol | 0.1 | 5.6 | 1127 | 1147.1 |
| 36 | 2-Methoxy-4-vinylphenol | 48.9 | 9.2 | 1320 | 1316.9 |
| 37 | Vanillin | 0.5 | 22.6 | 1393 | 1394 |
| 38 | Benzene acetaldehyde | 0.7 | 8.7 | 1036 | 1043 |
| 39 | 1,2-Benzenedimethanol | 1.9 | 15.2 | 1392 | 1385 |
| 40 | 2(4H)-Benzofuranone, 5,6,7,7a-tetrahydro-4,4,7a-trimethyl-, (R)- | 0.4 | 27.8 | 2466 | 2316 |
| 41 | 2,3-Pinanediol | 0.2 | 6.9 | 1244 | 1244 |
| 42 | 2-Decenal, (E)- | 0.3 | 5.3 | 1260 | 1259 |
| 43 | 2-Decen-1-ol, (E)- | 0.1 | 5.0 | 1268 | 1273.3 |
| 44 | Edulan II | 0.2 | 16.8 | 1328 | 1326 |
| 45 | Megastigmatrienone | 0.3 | 29.8 | 1435 | 1455 |
| 46 | Diethyl phthalate | 0.3 | 30.5 | 1590 | 1563 |
| 47 | 2H-Pyran, tetrahydro-2-(12-pentadecynyl oxy)- | 0.3 | 9.0 | 2245 | - |
| 48 | Maleimide | 0.3 | 15.7 | 2602 | 2244 |
| 49 | Dihydroedulan II | 0.2 | 18.3 | 1496 | 1526 |
| 50 | Eicosatetraenoic acid, phenylmethyl ester | 0.1 | 7.8 | 2270 | 3003 |
| Other compounds | 16.7 | - | - | ||
| Alcohol [No. 1] | |||||
| Alicyclic hydrocarbons [No. 2–12] | |||||
| Aliphatic hydrocarbons [No. 13] | |||||
| Oxygenated monoterpene hydrocarbons [No. 14–29] | |||||
| Oxygenated sesquiterpenes [No. 30–31] | |||||
| Phenolic compound [No. 32–39] | |||||
| Others [No. 40–50] |
| DPPH | |||
|---|---|---|---|
| IC50 (μg/mL) | μg TE/g EO | Reducing Power (IC50, μg/mL) | |
| EO | 450 ± 3.39 | 938.65 ± 9.68 | 84 ± 2.5 |
| BHT | 4.21 ± 0.08 | --- | 7.09 ± 0.1 |
| Quercetin | 1.07 ± 0.01 | --- | 2.29 ± 0.1 |
| Diameter of Inhibition Zone (mm) | ||||||
|---|---|---|---|---|---|---|
| Microorganism | Designated Strain Code | Essential Oil (10 μL/disc) | Cefoxitin (30 μg/disc) | Ceftriaxone (30 μg/disc) | Gentamicin (15 μg/disc) | |
| Native | Staphylococcus aureus | ATCC 25923 | 20.66 ±0.57 | 32 ± 0 | NT | 28 ± 1 |
| Klebsiella pneumoniae | ATCC 35657 | 15 ± 1 | NT | 26 ± 1 | NI | |
| Escherichia coli | ATCC 25922 | 15.33 ± 0.57 | NT | 27 ± 0 | 24.3 ± 0.4 | |
| Methicillin-resistant | Staphylococcus aureus | NCTC 12493 | 11.16 ± 0.76 | NI | NT | NI |
| MDR | Klebsiella pneumoniae | ATCC 700603 | 11.73 ± 0.64 | NT | NI | NI |
| Escherichia coli | ATCC 35218 | 12 ± 0.45 | NT | NI | NI | |
| Essential Oil | Gentamicin | |||||
|---|---|---|---|---|---|---|
| Microorganism | Designated Strain Code | MIC (mg/mL) | MBC (mg/mL) | MIC (mg/mL) | MBC (mg/mL) | |
| Native | Staphylococcus aureus | ATCC 25923 | 3.12 | 3.12 | 0.01 | 0.01 |
| Klebsiella pneumoniae | ATCC 35657 | 3.12 | 3.12 | 0.04 | 0.04 | |
| Escherichia coli | ATCC 25922 | 3.12 | 3.12 | 0.02 | 0.02 | |
| Methicillin-resistant | Staphylococcus aureus | NCTC 12493 | 6.25 | 6.25 | - | - |
| MDR | Klebsiella pneumoniae | ATCC 700603 | 6.25 | 6.25 | - | - |
| Escherichia coli | ATCC 35218 | 3.12 | 6.25 | - | - | |
| Microorganism | Designated Strain Code | FICI | Gain | |
|---|---|---|---|---|
| Native | Staphylococcus aureus | ATCC 25923 | 0.39 a | 4 |
| Klebsiella pneumoniae | ATCC 35657 | 0.27 a | 4 | |
| Escherichia coli | ATCC 25922 | 1.33 b | 3.33 | |
Publisher’s Note: MDPI stays neutral with regard to jurisdictional claims in published maps and institutional affiliations. |
© 2021 by the authors. Licensee MDPI, Basel, Switzerland. This article is an open access article distributed under the terms and conditions of the Creative Commons Attribution (CC BY) license (http://creativecommons.org/licenses/by/4.0/).
Share and Cite
Zine, H.; Ibrahimi, M.; Loqman, S.; Papazoglou, E.G.; Ouhaddou, S.; Elgadi, S.; Ouhdouch, Y.; Hakkou, R.; Adnani, M.E.; Ouhammou, A. Chemical Composition, Antioxidant, and Antibacterial Activities of Essential Oil of Atriplex semibaccata R.Br. Aerial Parts: First Assessment against Multidrug-Resistant Bacteria. Agronomy 2021, 11, 362. https://doi.org/10.3390/agronomy11020362
Zine H, Ibrahimi M, Loqman S, Papazoglou EG, Ouhaddou S, Elgadi S, Ouhdouch Y, Hakkou R, Adnani ME, Ouhammou A. Chemical Composition, Antioxidant, and Antibacterial Activities of Essential Oil of Atriplex semibaccata R.Br. Aerial Parts: First Assessment against Multidrug-Resistant Bacteria. Agronomy. 2021; 11(2):362. https://doi.org/10.3390/agronomy11020362
Chicago/Turabian StyleZine, Hamza, Manar Ibrahimi, Souad Loqman, Eleni G. Papazoglou, Soukaina Ouhaddou, Sara Elgadi, Yedir Ouhdouch, Rachid Hakkou, Mariam El Adnani, and Ahmed Ouhammou. 2021. "Chemical Composition, Antioxidant, and Antibacterial Activities of Essential Oil of Atriplex semibaccata R.Br. Aerial Parts: First Assessment against Multidrug-Resistant Bacteria" Agronomy 11, no. 2: 362. https://doi.org/10.3390/agronomy11020362
APA StyleZine, H., Ibrahimi, M., Loqman, S., Papazoglou, E. G., Ouhaddou, S., Elgadi, S., Ouhdouch, Y., Hakkou, R., Adnani, M. E., & Ouhammou, A. (2021). Chemical Composition, Antioxidant, and Antibacterial Activities of Essential Oil of Atriplex semibaccata R.Br. Aerial Parts: First Assessment against Multidrug-Resistant Bacteria. Agronomy, 11(2), 362. https://doi.org/10.3390/agronomy11020362

